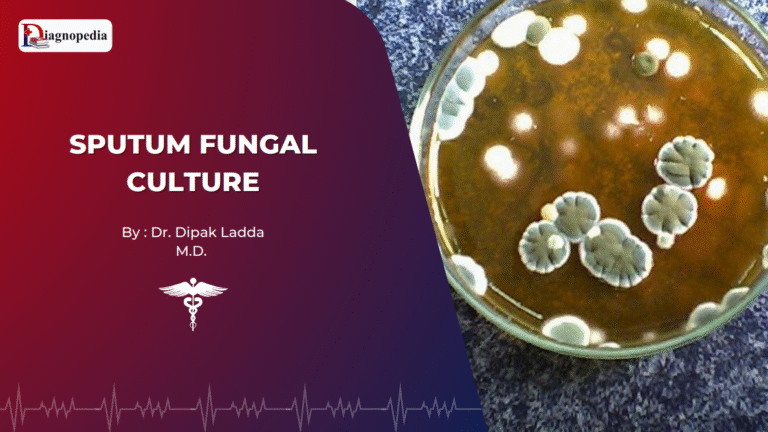
Sputum Fungal Culture Test

Library
Explore curated doctoral theses and clinical presentations— organized for clarity, built for quick reference, and trusted by the medical community.
Start Exploring 850+ Medical Topics
Ex: Cholesterol
Featured Topics

Overview Stool examination is a basic and essential laboratory investigation used to assess gastrointestinal health and detect a wide range...

Overview Stool examination is an essential laboratory investigation used to diagnose intestinal infections, inflammatory conditions, and parasitic infestations. It helps...

Overview The Stool Culture Test is a microbiological examination used to detect and identify pathogenic bacteria in the digestive tract...
Overview The Sputum Fungal Culture Test is a microbiological examination used to diagnose respiratory fungal infections. Unlike bacterial infections, fungal...

Overview Sputum examination is a non-invasive laboratory investigation used to assess diseases of the lower respiratory tract. Sputum is material...












